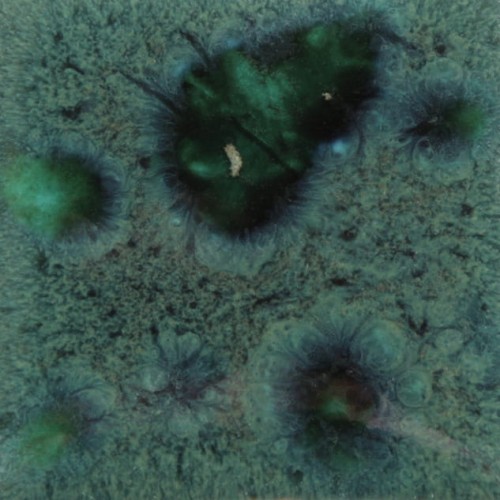
b1baf6544756aab62bddc0aad08b3c64

Filtry
473ml
Lista produktów
Jungle Gems™ 473 ml – szkliwa krystaliczne Mayco
Pojemność 473 ml sprawdzi się, gdy sięgasz po Jungle Gems™ regularnie albo szkliwisz większe powierzchnie. Efekty kryształów/fryty tworzą barwne wzory i „rozkwity” w wypale.
Wskazówki aplikacyjne
- Kryształy opadają – wstrząśnij, mieszaj i w razie potrzeby „podbieraj” kryształy z dna.
- Najczęściej stosuje się 2–3 warstwy; dosuszaj między warstwami.
- Przy wyższym wypale i na formach pionowych szkliwo może bardziej płynąć – ogranicz kryształy przy dole pracy i rozważ zabezpieczenie półki (płytka/odpadek biskwitu).
Zakres wypału (od–do w °C)
- Niski wypał: stożek 06–05 = 999–1046°C.
- Wypał wyższy (opcjonalnie): stożek 5–10 = 1196–1305°C (zalecane testy).
Naczynia użytkowe: na earthenware producent rekomenduje zastosowania dekoracyjne (tekstura/kraze). Dla stoneware – możliwe „dinnerware safe”, jeśli czerep jest wypalony do dojrzałości i powierzchnia nie ma tekstury.
Zobacz też: Jungle Gems™ 118 ml